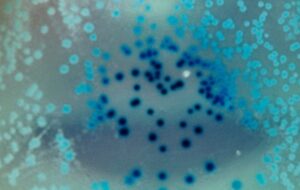
In a First, Bacteria Seen Storing Memories And Passing Them on For Generations

Space
Earth slammed by ultra-powerful ‘goddess particle’ cosmic ray, and we have no idea where it came from
Earth slammed by ultra-powerful ‘goddess particle’ cosmic ray, and we have no idea where it came from Researchers have detected

Earth slammed by ultra-powerful ‘goddess particle’ cosmic ray, and we have no idea where it came from Researchers have detected

Scientists Find ‘Kill Switch’ That Activates Cancer Cell Death in The Lab Scientists have figured out a way to detonate
In a First, Bacteria Seen Storing Memories And Passing Them on For Generations A single-celled organism with no brain or

Chinese rocket carrying ‘undisclosed’ object crashed into the moon and left twin craters, study claims A mysterious rocket that crashed